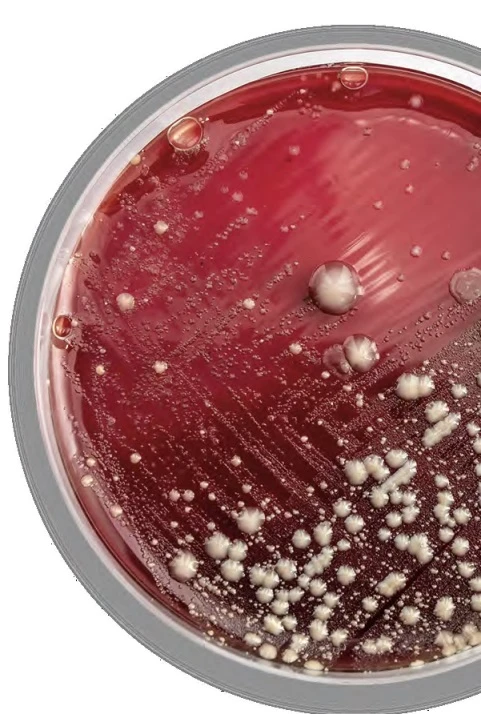
Culture & Sensitivity - Stool

تفاصيل التحليل
مزرعة وحساسية البراز
فحص دقيق لتحديد البكتيريا أو الطفيليات المسببة للإسهال والاضطرابات الهضمية، مما يساعد في وصف العلاج الأمثل لاستعادة توازن الأمعاء وصحة الجهاز الهضمي بشكل كامل.
الصورة التوضيحية المرتبطة بهذا التحليل